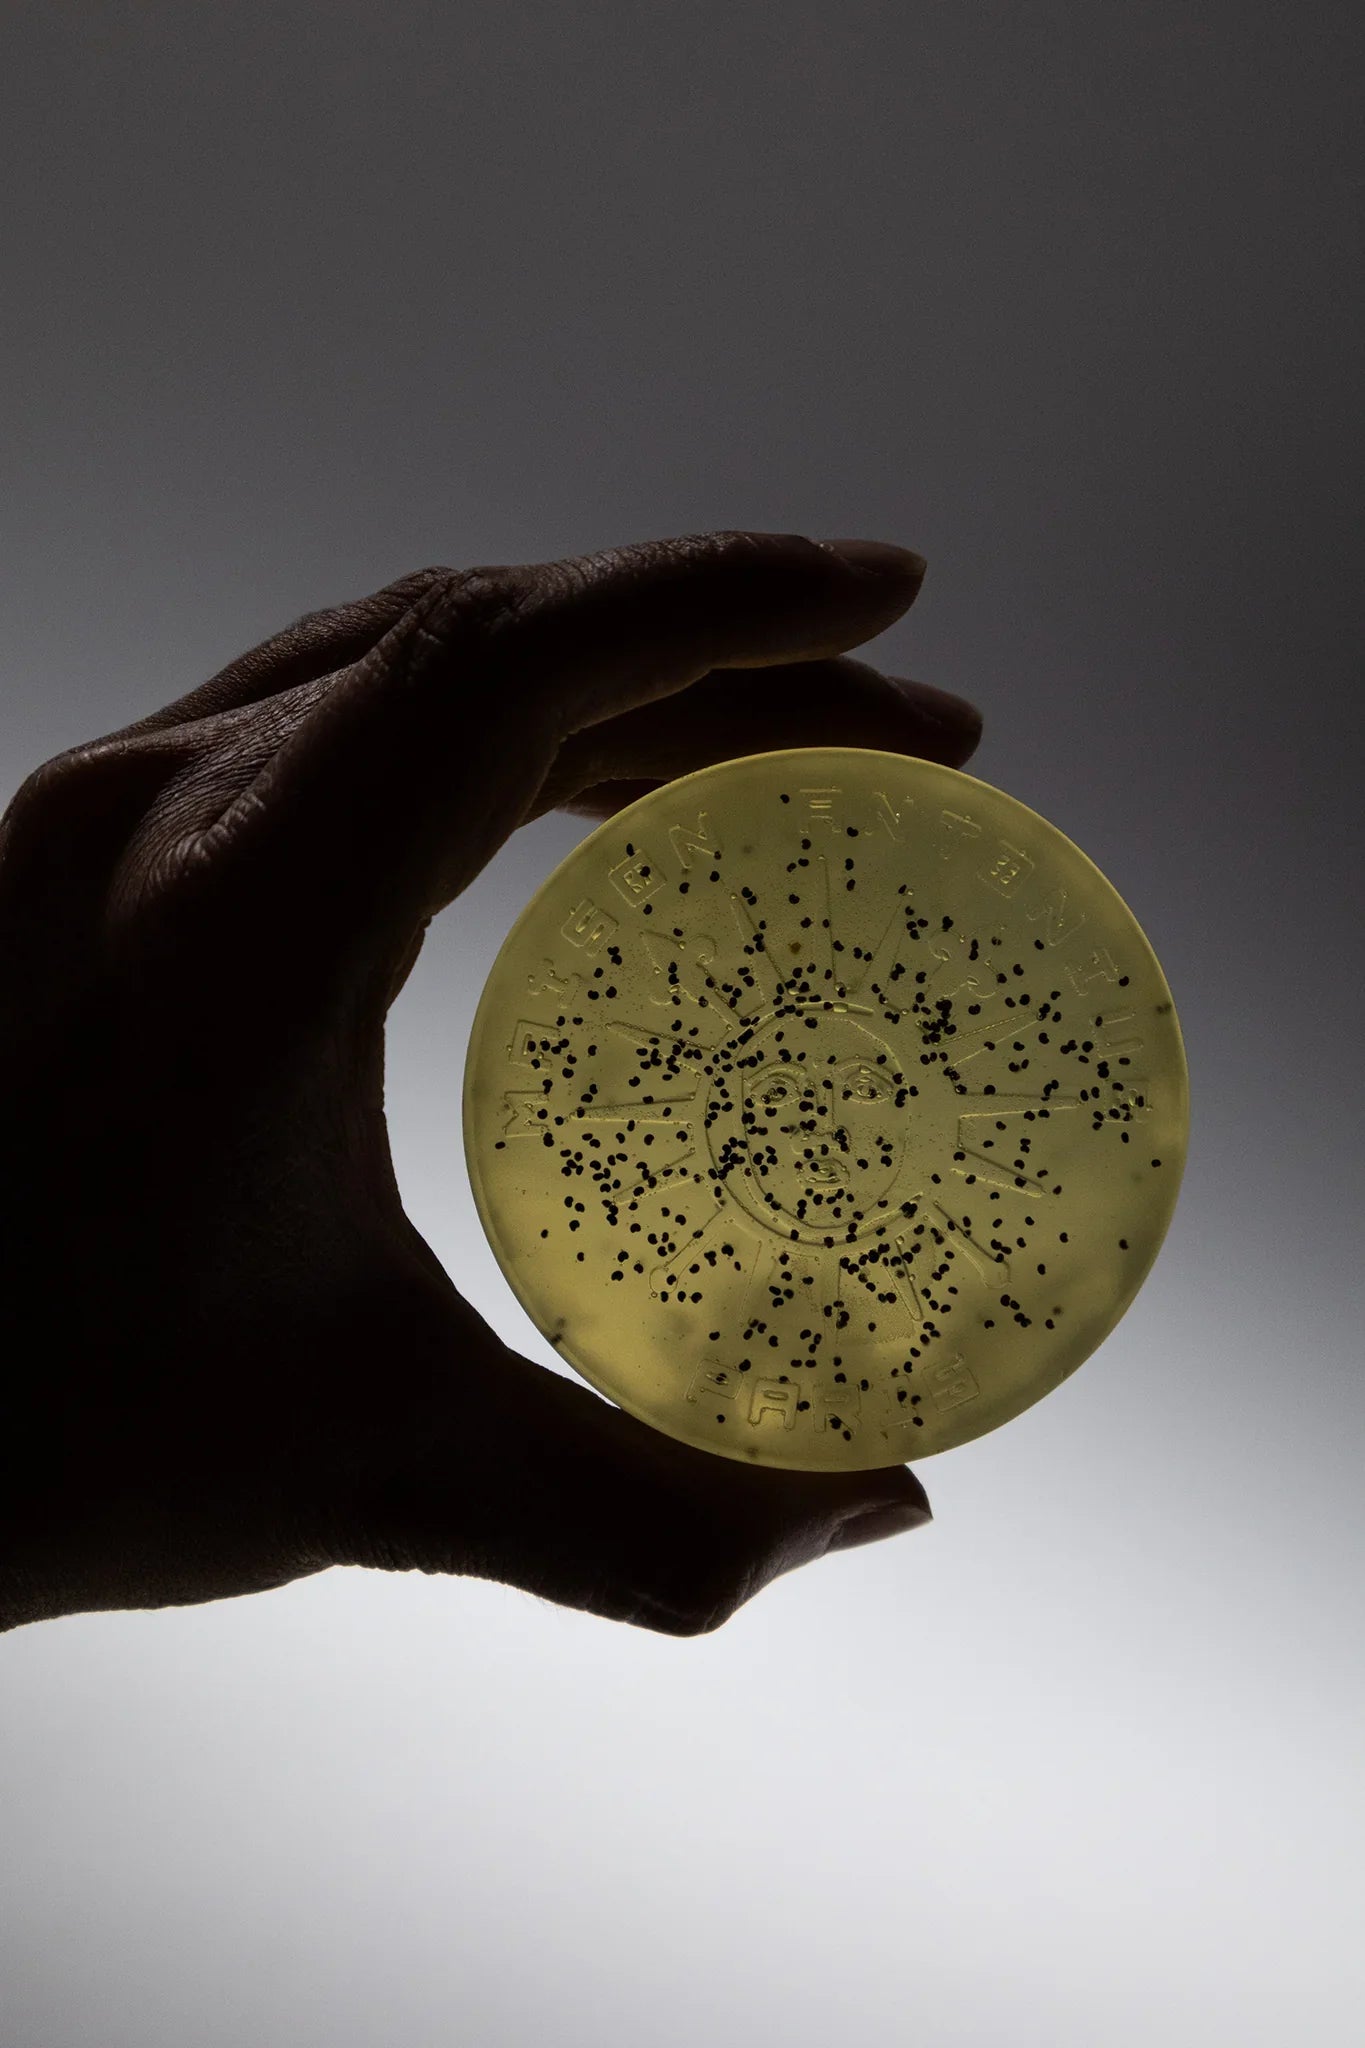

Awaken your senses with Savon Vitalité (Vitality), a refreshing blend of cooling peppermint, soothing aloe vera, nourishing hemp seed oil, and gently exfoliating poppy seeds. This artisanal soap energizes the skin while promoting natural renewal, leaving you with a clean, smooth, and vibrant glow. Savon Vitalité is ideal for normal to oily, combination, and tired skin types. Its cooling, exfoliating, and balancing properties make it a great choice for those seeking clarity and refreshment in their skincare routine.
Key Benefits:
Revives dull, tired skin
Cools and refreshes with peppermint oil
Hydrates without heaviness
Gently exfoliates for a soft, radiant feel
Aloe Vera
-
Soothes irritated or sunburned skin
-
Hydrates deeply without clogging pores
-
Promotes healing of minor cuts and inflammation
-
Rich in vitamins A, C, E, and enzymes that support skin repair
Hemp Seed Oil
-
Balances oily skin while keeping it moisturized
-
Packed with omega-3 and omega-6 fatty acids
-
Helps reduce inflammation and redness
-
Promotes a healthy skin barrier, great for eczema or dry skin
Peppermint Essential Oil
-
Provides a cooling, tingling sensation that feels refreshing
-
Naturally antibacterial and antifungal
-
Helps with acne, itchiness, and clogged pores
-
Stimulates circulation for revived, glowing skin
Poppy Seeds (Exfoliant)
-
Gently removes dead skin cells
-
Boosts cell turnover for smoother, brighter skin
-
Adds a natural texture and invigorating massage effect
Awaken your senses with Savon Vitalité (Vitality), a refreshing blend of cooling peppermint, soothing aloe vera, nourishing hemp seed oil, and gently exfoliating poppy seeds. This artisanal soap energizes the skin while promoting natural renewal, leaving you with a clean, smooth, and vibrant glow. Savon Vitalité is ideal for normal to oily, combination, and tired skin types. Its cooling, exfoliating, and balancing properties make it a great choice for those seeking clarity and refreshment in their skincare routine.
Key Benefits:
Revives dull, tired skin
Cools and refreshes with peppermint oil
Hydrates without heaviness
Gently exfoliates for a soft, radiant feel
Aloe Vera
-
Soothes irritated or sunburned skin
-
Hydrates deeply without clogging pores
-
Promotes healing of minor cuts and inflammation
-
Rich in vitamins A, C, E, and enzymes that support skin repair
Hemp Seed Oil
-
Balances oily skin while keeping it moisturized
-
Packed with omega-3 and omega-6 fatty acids
-
Helps reduce inflammation and redness
-
Promotes a healthy skin barrier, great for eczema or dry skin
Peppermint Essential Oil
-
Provides a cooling, tingling sensation that feels refreshing
-
Naturally antibacterial and antifungal
-
Helps with acne, itchiness, and clogged pores
-
Stimulates circulation for revived, glowing skin
Poppy Seeds (Exfoliant)
-
Gently removes dead skin cells
-
Boosts cell turnover for smoother, brighter skin
-
Adds a natural texture and invigorating massage effect
-
Olive Oil, Palm Oil, Coconut Oil, Safflower Oil, Glycerin, Natural Hemp Seed Oil, Aloe Vera Gel, Water, Sodium Hydroxide, Sorbitol, Propylene Glycol, Sorbitan Oleate, Oat Protein, Peppermint Essential Oil, Poppy Seed
Please note: Not recommended for infants or toddlers. May be okay for teens (13+) with oily or acne-prone skin, depending on skin sensitivity.
Olive Oil, Palm Oil, Coconut Oil, Safflower Oil, Glycerin, Natural Hemp Seed Oil, Aloe Vera Gel, Water, Sodium Hydroxide, Sorbitol, Propylene Glycol, Sorbitan Oleate, Oat Protein, Peppermint Essential Oil, Poppy Seed
Please note: Not recommended for infants or toddlers. May be okay for teens (13+) with oily or acne-prone skin, depending on skin sensitivity.